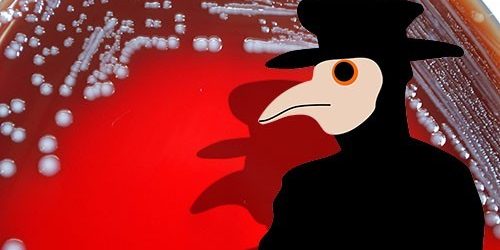

4 сентября 2019 года, 09:01
В Европе растет количество заболевших корью. За первые шесть месяцев 2019 года выявлено почти 90 000 случаев кори в 48 из 53 стран Европейского региона — больше, чем за весь 2018 год (84 462 случая). Также зарегистрировано 37 смертей. В связи с этим ВОЗ объявила чрезвычайную ситуацию второй категории и активизировала усилия по борьбе с заболеванием.
В начале августа статус стран, свободных от кори, потеряли Албания, Чешская Республика, Греция и Великобритания. Это говорит об утрате контроля над иммунизацией против кори.
«Если не будет обеспечен и сохранен высокий охват иммунизацией в каждом сообществе, то ненужные страдания и для детей, и для взрослых неизбежно продолжатся. Нельзя будет избежать и трагических смертей», — заявил Гюнтер Пфафф (Günter Pfaff), председатель Европейской региональной комиссии по верификации элиминации кори и краснухи, подготовившей доклад.
В разных регионах России также регистрируются вспышки заболеваемости корью. По информации Роспотребнадзора, в 2018 году было зарегистрировано 2538 случаев, за январь-апрель 2019 — 872 случая, причем половина заболевших проживает в Москве и Московской области. В настоящее время эпидемическая ситуация находится под контролем, а в большинстве случаев заболевание завезено из проблемных в отношении кори стран. Наибольшая доля заболевших приходится на непривитых по религиозным соображениям и цыган, которые ведут кочевой образ жизни.
Корь является одним из самых заразных заболеваний в мире, потенциально смертельным, но полностью предотвратимым. Единственную защиту обеспечивает своевременная прививка двумя дозами КПК (корь, эпидемический паротит и краснуха). В России первая инъекция делается детям в возрасте 12 месяцев, а ревакцинация — в 6 лет.
Поскольку некоторые дети (например, больные раком или имеющие проблемы с иммунной системой) не могут быть вакцинированы, для их защиты и формирования так называемого коллективного иммунитета 95% населения должны быть иммунизированы обеими дозами КПК.
«Мы много говорим о непривитых и людях, настроенных против вакцинации, и о рисках для них и их детей, но на самом деле наибольшие риски у тех, кто не может быть привит. Они полностью зависимы от общества», — пояснилпрофессор Эндрю Поллард (AndrewPollard) из Оксфордского университета.
Согласно докладу ВОЗ, охват полной иммунизацией Европейского региона составляет 91%. Исследование, проведенное в 2017 году, показало, что падение охвата всего лишь на 5% может привести к трехкратному увеличению числа случаев заболевания корью.
Эксперты связывают неадекватный уровень вакцинации с антипрививочным движением. Хотя предоставляемая противниками прививок дезинформация в отношении КПК полностью разоблачена, они продолжают вести активную пропаганду в социальных сетях и на других онлайн-платформах. Некоторые платформы уже приняли меры. В частности, Pinterest 28 августа анонсировал ужесточение своих правил борьбы с мифами о вакцинах.
«Социальные сети, вероятно, станут основными источниками информации для будущих поколений родителей. Мы рассматриваем это как критически важную проблему, решение которой требует наших коллективных усилий», — сказал доктор Тедрос Адханом Гебрейесус (Tedros Adhanom Ghebreyesus), генеральный директор ВОЗ.
Он отметил, что вакцинация спасает, по меньшей мере, 2 миллиона жизней в год. Поэтому правительства должны реагировать на проблемы и потребности родителей, а также создавать системы здравоохранения, которым можно было бы доверять.
Врачи подчеркивают, что никогда не поздно привиться от кори. Они настоятельно призывают сделать это, особенно если планируется посещение неблагополучных в отношении кори стран.